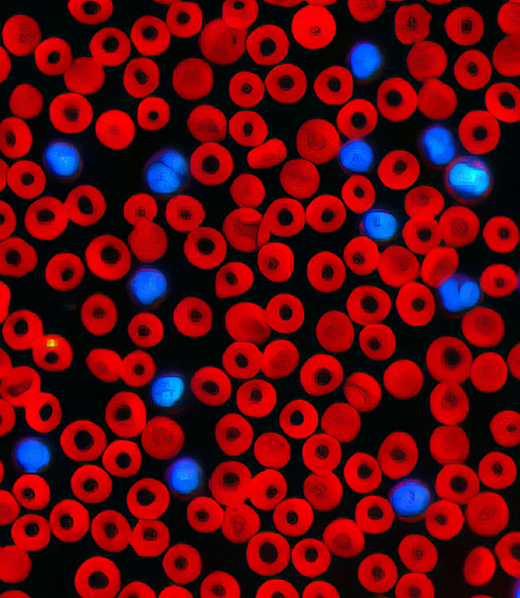
A microscopic view of blood cells.

Analizzatore cellulare IDEXX inVue Dx
Le cellule come non le hai mai viste prima.
Esegui diagnosi e intervieni, in tempo reale, su tipi di cellule che potrebbero essere clinicamente rilevanti, senza dover allestire un vetrino.

Citologia. Morfologia. In tempi da record.
L’analizzatore cellulare IDEXX inVue Dx fornisce, in tempo reale, risultati automatizzati di morfologia ematologica e citologia auricolare, con la stessa accuratezza dei laboratori di riferimento, nel giro di pochi minuti. Una procedura senza allestimento manuale del campione garantisce coerenza e accuratezza senza dover ricorrere al processo di preparazione dello stesso. L'analisi multidimensionale delle cellule nel loro stato naturale, combinata con l’uso di molteplici lunghezze d’onda di luce e fluorescenza, consente di illuminare singoli elementi cellulari e di ottenere informazioni diagnostiche più approfondite rispetto ai metodi tradizionali con allestimento su vetrino.

Morfologia ematologica
Analisi automatizzata dei parametri morfologici, tra cui:
- piastrine anche in presenza di aggregati
- sferociti
- agglutinazione dei globuli rossi
- neutrofili immaturi
Integrata con i risultati degli analizzatori per ematologia ProCyte One e ProCyte Dx.

Citologia auricolare
Risultati semiquantitativi di entrambe le orecchie in un unico esame per:
- batteri bastoncellari
- batteri coccoidi
- lieviti
Rileva la presenza di:
- Globuli bianchi
- Acari; un'immagine dinamica del campione viene inclusa nel referto

Prossimamente: campioni citologici ottenuti per agoaspirato
Fornisce obiettività all'interpretazione soggettiva: identifica, misura e quantifica le cellule come non hai mai fatto prima.

Un’offerta sempre più variegata
IDEXX inVue Dx non è solo un analizzatore, ma una piattaforma diagnostica dotata di un menù sempre più ampio.
Scopri quante informazioni approfondite puoi ottenere con l'analizzatore IDEXX inVue Dx.
Progettato per offrire un punto di vista differente.
È nato come un modo per vedere le cellule senza dover allestire un vetrino.1 Ma si è evoluto in molto di più.
Visualizza fino a 20 volte più cellule.1
Analizza più dettagli di quanti ne potresti ottenere con un vetrino. Invece di visualizzare solo una parte del campione, ottieni una visione più completa.
100× più secondi pareri.
Ricevi risultati completi e indicazioni sui passi successivi grazie alla nostra intelligenza artificiale basata sul deep learning, addestrata da centinaia di patologi diplomati.
Un nuovo modo di lavorare.
Analizza le cellule nel loro stato naturale, utilizzando diverse lunghezze d'onda di luce e fluorescenza, in meno di un minuto di intervento operativo.
Oggettività e ripetibilità.
Non devi preoccuparti della contaminazione dei coloranti o della soggettività dell’interpretazione. Ottieni risultati dettagliati e accurati, ogni volta.
Come viene utilizzato nelle cliniche.
Quando i team veterinari raccontano ciò che funziona nelle loro cliniche, i risultati parlano da soli. Ecco cosa dicono dell’analizzatore IDEXX inVue Dx.
“inVue Dx è diventato esattamente ciò che speravamo: è efficiente e affidabile, un elemento imprescindibile del processo diagnostico.”
Nicole Schaff, responsabile di clinica
“inVue Dx fornisce costantemente risultati rapidi e affidabili. Lo utilizzo di continuo: la sua precisione mi dà sicurezza nella diagnosi e nel discutere i piani terapeutici con i clienti.”
Kayla Radtke, DVM
Non abbiamo reinventato il microscopio.
Abbiamo reinventato il flusso di lavoro.
Analizza 10.000 cellule nello stesso tempo impiegato per preparare un singolo vetrino.2 Ottieni risultati in pochi minuti. Carica e analizza.

Ordina il test tramite il tuo software gestionale.
L’addebito è automatico e le informazioni del paziente vengono inviate alla IDEXX VetLab Station.

Prepara il campione.
Aggiungi il campione alla cartuccia. Il processo richiede meno di un minuto di intervento manuale, in questo modo tu e il tuo staff potete dedicare più tempo ai pazienti.

Inserisci e premi avvio.
Noi pensiamo al resto. L'analizzatore inizierà a lavorare e ti avviserà non appena avrà completato il processo.

Ottieni i risultati in pochi minuti. Davvero.
Risultati completi, passaggi successivi concreti e una galleria di immagini composite di facile consultazione per i clienti.
Risparmia tempo prezioso.
Con meno di un minuto di intervento manuale e risultati completi in pochissimo tempo, tu e il tuo staff potrete fare ciò che amate di più: dedicare tempo ai pazienti.
Comunica i risultati in modo semplice.
Risultati, passaggi successivi e considerazioni diagnostiche sono inclusi in un referto integrato di facile lettura, per agevolare la comunicazione con i proprietari durante la visita del paziente.
Non perderti niente.
Risultati, immagini composite e addebiti vengono salvati automaticamente nelle cartelle dei pazienti, su VetConnect PLUS e nel tuo PIMS. Facile, no?
Piccole dimensioni.
Grandi vantaggi.
Profondità: 34,3 cm
Altezza: 30,9 cm
Larghezza: 23,6 cm

Un nuovo membro nel team della tua clinica.
L'analizzatore IDEXX inVue Dx è progettato e costruito per connettersi facilmente ai tuoi analizzatori in clinica IDEXX, ai Laboratori di Riferimento e a VetConnect PLUS. Aiutando la tua clinica a registrare risultati, immagini e addebiti in modo più efficiente, ti permette di dedicare più tempo ai tuoi pazienti.




Ti piacerebbe vedere le cellule come non le hai mai viste prima?
Compila il modulo per essere ricontattato da un rappresentante IDEXX.
Perché scegliere l’analizzatore cellulare IDEXX inVue Dx?
- Flusso di lavoro senza allestimento manuale del vetrino
- Citologia e morfologia ematologica automatizzate e in tempo reale
- Un menu in continua espansione
Nota: questa pagina web contiene dichiarazioni previsionali soggette a rischi e incertezze. Per ulteriori informazioni, consultare la nostra nota di avvertenza.
Riferimenti bibliografici
- Dati in archivio presso IDEXX Laboratories, Inc. Westbrook, Maine, Stati Uniti: una singola analisi con l'analizzatore IDEXX inVue Dx fornisce informazioni diagnostiche equivalenti alla lettura completa di circa 10 vetrini tradizionali di citologia auricolare o 20 vetrini tradizionali di morfologia ematologica.
- Dati in archivio presso IDEXX Laboratories, Inc. Westbrook, Maine, Stati Uniti: l'analizzatore cellulare IDEXX inVue Dx classifica 10.000 globuli rossi ad ogni test di morfologica ematologica.